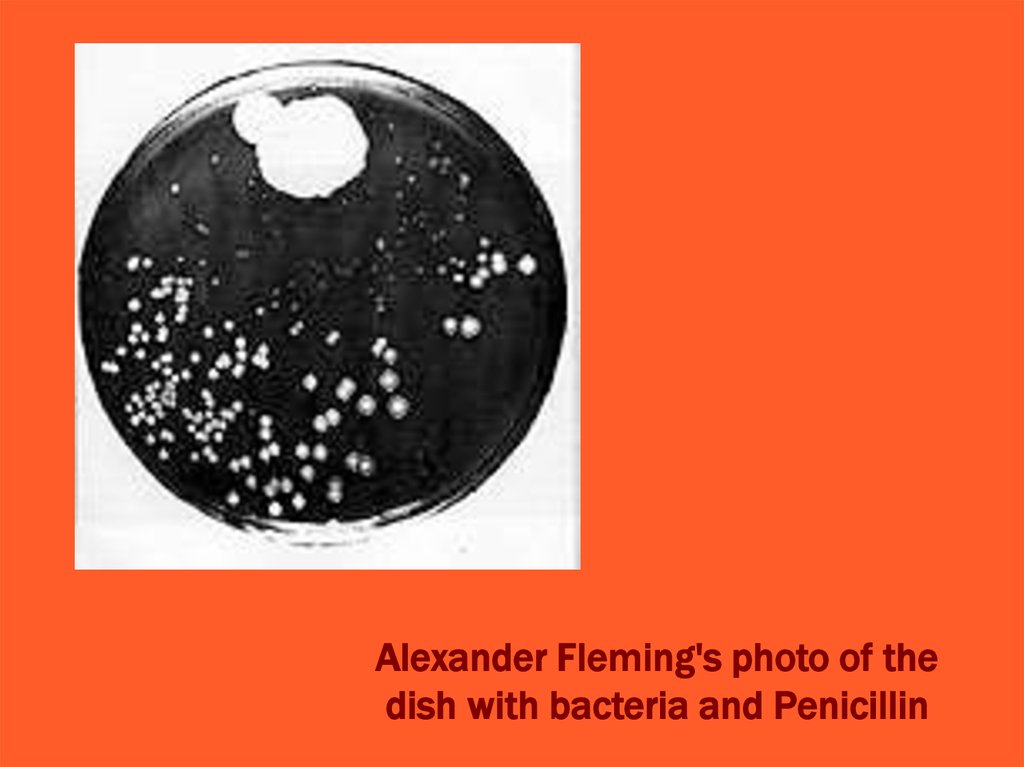

Похожие презентации:
Образы науки. Часть 1
1.
ОБРАЗЫ НАУКИЧасть 1
Периодическая таблица элементов в картинках
2.
3.
Периодическая таблица элементов в картинках4.
The Artof Science,
the Science
of Art
5.
The Artof Science,
the Science
of Art
6.
http://www.flickr.com/photos/craftwerk/389880784/
Fabric Brain Art: This is Your Brain on Wool
7.
Левое иправое
полушария
8.
9.
http://news.nationalgeographic.com/news/2011/02/pictures/110217-bestscience-pictures-2010-scivisvisualization-illustration-photography/
Атака бактерии бактериофагом «в формате 3-D»
10.
3-D модельвируса
11.
http://news.nationalgeographic.com"Save
/news/2010/02/photogalleries/10021
8-best-science-pictures/
Our Earth, Let’s Go Green"
12.
"Jellyfish Burger"В чем
идея?
Медуза – намек на
угрозу глобального
потепления
13.
"Microbe vs.Mineral"
14.
"Back tothe Future"
Микроскопические
морские водоросли
как образы
солнечных батарей
15.
Solar panels and the end of a robotic arm hover highabove the city lights of Europe in a newly released
picture taken from the International Space Station.
16.
Вулканическиекратеры на Марсе
17.
http://asianhistory.about.com/od/asianinventions/tp/ModernAsian-Inventions.htm
1413 A.D. - Invention of the ironclad "turtleboat," Korea
18.
http://www.arabianbusiness.com/photos/greatest-scientificinventions-93160.html?img=0
Science Museum employee Katie Maggs holds
a 19th century X-RAY tube during a photocall at
the Science Museum in London, England
19.
One of the 10 nominations for the greatestinventions, the Apollo 10 capsule
20.
the Electric Telegraph21.
the Model T Ford22.
the Stephenson's Rocket23.
24.
ИзображениеЗемли с расстояния
в 6,1 млрд. км.
Земля – «бледноголубая точка».
25.
NautilusShell (the
Fibonacci
Spiral)
26.
Eagle Nebula, Pillars ofCreation - Hubble Telescope
27.
28.
The Mendelian Law29.
http://newdsart.blogspot.com/2012/01/genetics.htmlКак обозначено
наследование
случайных черт?
30.
НиколайКоперник
Кто это?
31.
Diagram of theCopernican system
32.
Kepler's model toexplain the relative
distances of
the planets from
the Sun in the
Copernican System
33.
Galileo's telescope up close34.
http://www.newscientist.com/gallery/dn16842-galileo-exhibit/3
This sundial
has nine
different faces.
All the dials on
all the different
faces show
exactly the
same time, no
matter which
face is used.
Polyhedral dial
(16th century)
35.
Brass astrolabe (9th century)36.
Orrery(18th
century)
37.
Planetary motion tapestry (15th century)38.
Navicula dial(15th century)
39.
Galileo's legacy:The technology
of the heavens
Lunar Observations
by Galileo (1609)
40.
Graphometer (17th century)41.
Armillarysphere (1578)
42.
Middle finger ofGalileo's right hand
43.
Что это?44.
Alexander Fleming's photo of thedish with bacteria and Penicillin
45.
Fleming's penicillin mould, 1935.46.
A «map» ofthe body
47.
http://brainmind.com/ParietalLobe.html
Motor Homunculus
- Penfield and
Rasmussen

Образование
Образование








